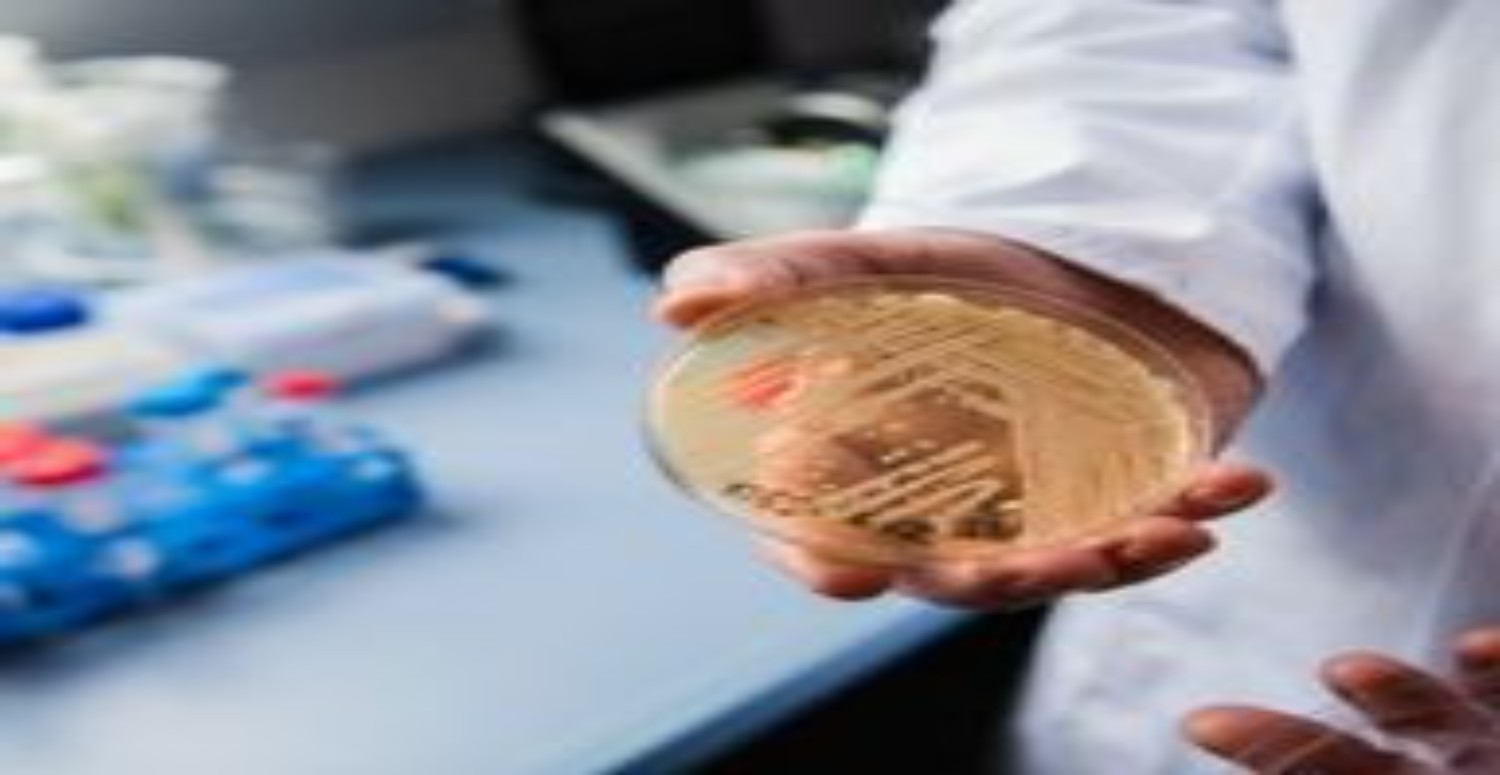
candida auris

Safra kesesi, karaciğerin altında bulunan ve safra adı verilen sindirim sıvısını depolayan küçük bir organdır. Safra, yağların sindirimine yardımcı olur. Candida Auris, safra kesesinin çıkışını tıkadığında şiddetli ağrı, bulantı, kusma, sarılık gibi belirtiler ortaya çıkar. Peki Candida Auris önlenebilir mi? Belirtileri nelerdir? Kimlerde görülür, nasıl teşhis edilir ve nerede bulunur? İşte tüm detaylar...
CANDİDA AURİS NEREDE BULUNUR?
Candida Auris, ilk kez 2009 yılında Japonya’da keşfedildi. O zamandan beri, ABD, İngiltere, İspanya, Hindistan, Pakistan, Güney Afrika, Venezuela, Kolombiya, Kenya, İsrail, Kuveyt, Umman, Güney Kore, Çin, Avustralya ve Kanada gibi birçok ülkede salgın haline geldi.
Candida Auris, hastane ortamlarında yatak rayları, sandalyeler, sondalar ve diğer tıbbi ekipmanlar üzerinde yaşayabilir ve sağlık çalışanlarının elleriyle bulaşabilir. Bu nedenle, Candida Auris enfeksiyonu olan hastaların izole edilmesi ve hijyen kurallarına uyulması gerekmektedir.
CANDİDA AURİS KİMLERDE GÖRÜLÜR?
Candida Auris, özellikle bağışıklık sistemi zayıf olan, diyabetli, yaşlı, yoğun bakımda yatan veya uzun süreli antibiyotik kullanan kişilerde görülür.

Bu kişiler, Candida Auris’in neden olduğu ciddi ve ölümcül enfeksiyonlara karşı daha savunmasızdır. Candida Auris, kan dolaşımına girerek sepsis, koma, organ yetmezliği ve ölüme yol açabilir.
CANDİDA AURİS NASIL TEŞHİS EDİLİR?
Candida Auris, tanı için ultrason, kan testi, MRCP gibi yöntemler kullanılır. Ultrason, safra kesesindeki taşların görüntülenmesini sağlar. Kan testi, karaciğer ve pankreas fonksiyonlarını değerlendirir.

MRCP, manyetik rezonans görüntüleme ile safra yollarının incelenmesini sağlar. Ancak, Candida Auris, bazen diğer Candida türleriyle karıştırılabilir ve yanlış tanıya neden olabilir. Bu nedenle, Candida Auris’in doğru ve hızlı bir şekilde tespit edilmesi için gelişmiş laboratuvar testleri gerekmektedir.
CANDİDA AURİS BELİRTİLERİ NELERDİR?
Candida auris, çok ilaca dirençli, ciddi ve ölümcül enfeksiyonlara neden olan bir mantar türüdür. Candida auris enfeksiyonunun belirtileri, enfeksiyonun yerleştiği bölge, hastanın bağışıklık sistemi ve enfeksiyonun ciddiyeti gibi faktörlere bağlı olarak değişebilir. Ancak, enfeksiyonun yaygın belirtileri şunlardır:
Ateş: Enfekte olan kişide yüksek ateş görülebilir.
Titreme: Enfekte olan kişide titreme ve üşüme hissi olabilir.
Terleme: Enfekte olan kişide aşırı terleme olabilir.

Ağrı: Enfekte olan kişide karın, göğüs, sırt veya baş bölgesinde ağrı olabilir.
Bulantı ve kusma: Enfekte olan kişide mide bulantısı ve kusma olabilir.
Sarılık: Enfekte olan kişide cilt ve gözlerde sararma olabilir.
Genel bir yorgunluk ve halsizlik hissi: Enfekte olan kişide enerji düşüklüğü ve bitkinlik olabilir.
Candida auris enfeksiyonu, kan dolaşımına girerek sepsis, koma, organ yetmezliği ve ölüme yol açabilir
CANDİDA AURİS NASIL TEDAVİ EDİLİR?
Candida Auris, tedavi için ilaç, şok dalga tedavisi, ERCP, laparoskopik veya açık cerrahi gibi yöntemler kullanılır. İlaç tedavisi, safra kesesindeki taşların eritilmesini amaçlar, ancak uzun süreli ve başarı oranı düşüktür. Şok dalga tedavisi, safra kesesindeki taşların parçalanmasını amaçlar, ancak büyük taşlar için uygun değildir.

ERCP, endoskopik olarak safra yollarındaki taşların alınmasını sağlar, ancak safra kesesindeki taşları çıkarmaz. Laparoskopik veya açık cerrahi, safra kesesinin tamamen alınmasını sağlar, ancak komplikasyon riski vardır. Candida Auris, pek çok antifungal ilaca dirençli olduğu için tedavi zor ve başarısız olabilir.
CANDİDA AURİS ÖNLENEMEZ Mİ?
Candida Auris, belirti vermeden sinsice ilerleyen ve ciddi sonuçlara yol açabilen bir mantar türüdür. Bu nedenle, Candida Auris enfeksiyonundan korunmak için bazı önlemler almak gerekir. Bunlar şunlardır:
* Hastane ortamlarında hijyen kurallarına uymak, elleri sık sık yıkamak, dezenfektan kullanmak, enfekte hastalarla temas etmemek veya koruyucu ekipman giymek.
* Bağışıklık sistemini güçlendirmek için sağlıklı ve dengeli beslenmek, vitamin ve mineral takviyesi almak, stresten uzak durmak, uyku düzenine dikkat etmek, egzersiz yapmak.

* Diyabeti kontrol altında tutmak için kan şekeri seviyesini ölçmek, ilaçları düzenli kullanmak, şekerli ve unlu gıdalardan kaçınmak, lifli gıdalar tüketmek.
* Antibiyotik kullanımını sınırlamak, doktor tavsiyesi olmadan antibiyotik almamak, antibiyotik tedavisini yarıda bırakmamak, antibiyotikleri başkalarıyla paylaşmamak.
* Candida Auris enfeksiyonundan şüphelenildiğinde vakit kaybetmeden doktora başvurmak, doğru tanı ve tedavi için gerekli testleri yaptırmak, tedaviye uyum sağlamak.

